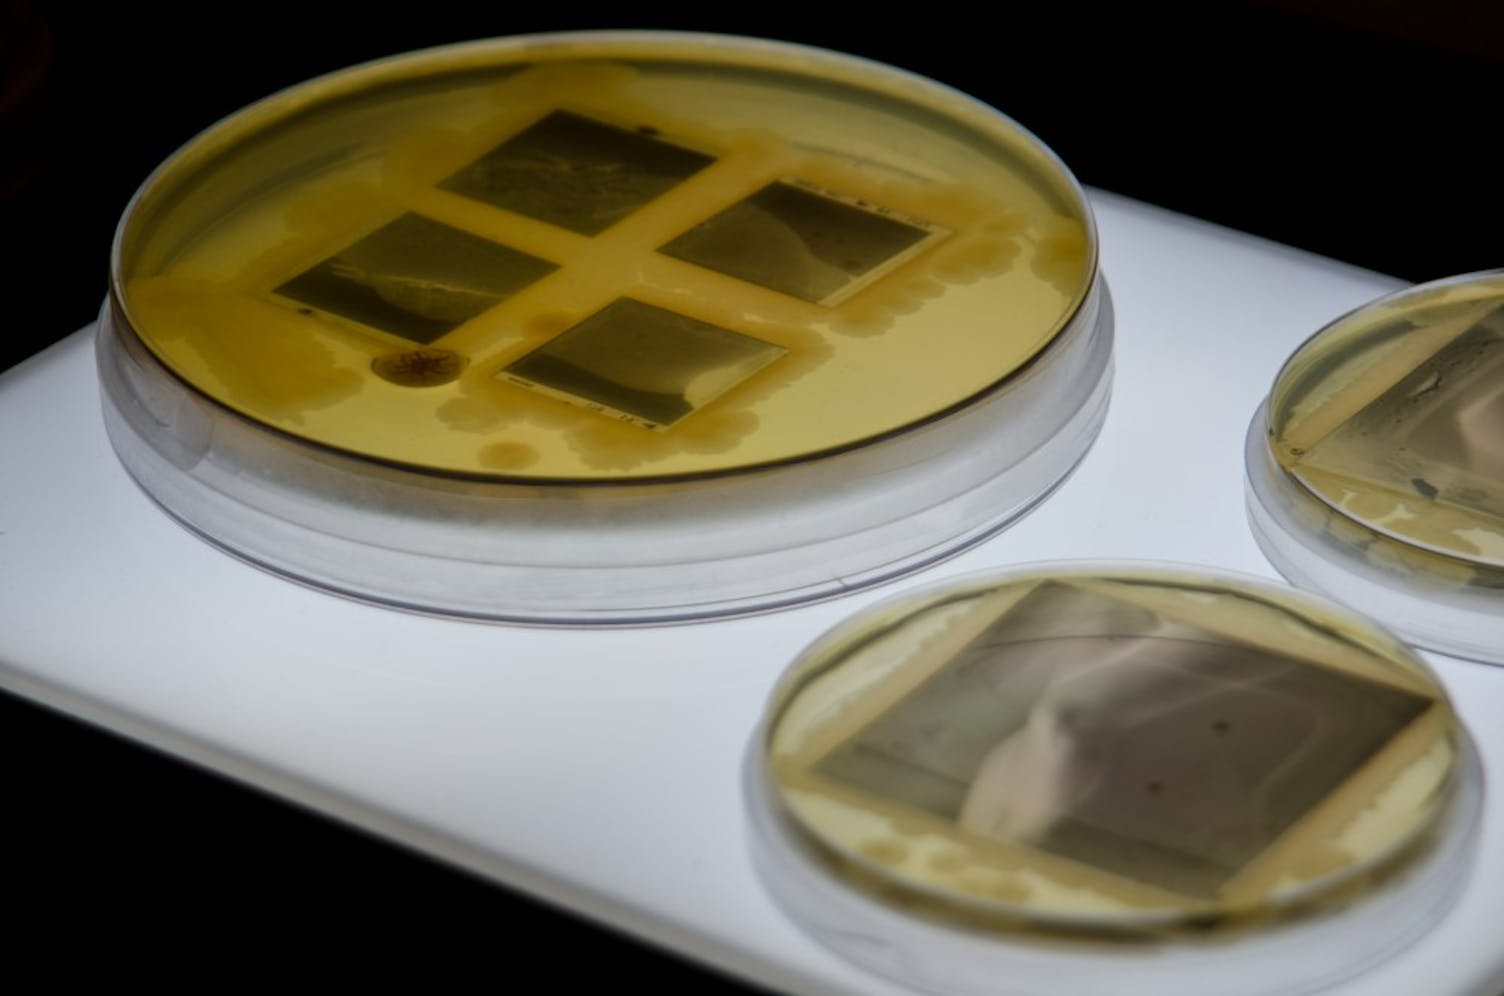
biodesign-2505.jpg

Medical gauze, air filtration masks, and photos of bacteria may not evoke images of art, but these were exactly the materials that Penn School of Design students used for their final projects displayed at the Esther Klein Gallery last week.
Students in FNAR-268: “Biological Design,” apply scientific concepts to product design. The course is the country’s only BioDesign class offered in an undergraduate design school, PennDesign professor Orkan Telhan said. Biology professor Karen Hogan and Telhan teach the course, which has been offered every fall since 2015.
Each group of students comes up with a product designed for a speculative world, such as a world after a large volcanic eruption, or a situation where humans have to migrate to Mars. Students develop these storylines to spark discussion about the social and ethical issues behind their products.
Students showcased their final projects on Dec. 6 at the Esther Klein Gallery located at 3600 Market Street.
College sophomore Jennifer Higa was part of a group that studied the anatomy of an eye and learned that each person's iris pattern is unique.
The group created a speculative world where humans moved to Mars but were not welcomed by Martians. They developed biometric identifiers — essentially glasses resembling the iris of a person’s eye — for the Martians to distinguish themselves from outsiders.
“Someone interpreted it as anti-immigration because of the current state of politics when we were trying to focus more on anti-gentrification,” Higa said. “It was interesting to see how people reacted to the social and political implications of the project.”
The class meets twice a week, with one day dedicated to studio and design work and the other to lab work, where students can work with bacteria. College junior Renee Hastings, who worked on the project with Higa, said her group faced delays when bacteria didn’t grow as expected.
“When you’re drawing, you have complete control over how it’s going to turn out,” Hastings said. “But you can’t control how bacteria grows, so there’s a lot less freedom.”

College junior Cristina Vaca worked on designing an air filtration mask, which was created in response to a speculative world where a volcano in Yellowstone National Park erupted and left the planet covered in ashes.
Without sunlight, Vaca’s group predicted crop failure across the country. The group fermented mycelium, the root of mushrooms, to create edible protein in response to the food shortage.
Director of Undergraduate Programs in Fine Arts Matt Neff said professors are working on expanding the BioDesign field at Penn. Neff and Telhan are working to create a follow-up course for the class, but have yet to finalize any plans.
“Art and design do bleed into these other subject areas,” Neff said. “We are actively talking about what the next offering could be and mapping out a program around it.”
Vaca said she hopes the design school will offer more integrated courses like BioDesign.
“Penn talks a lot about how interdisciplinary they are, but I think a lot of those programs are more focused in other departments other than design,” she said.




